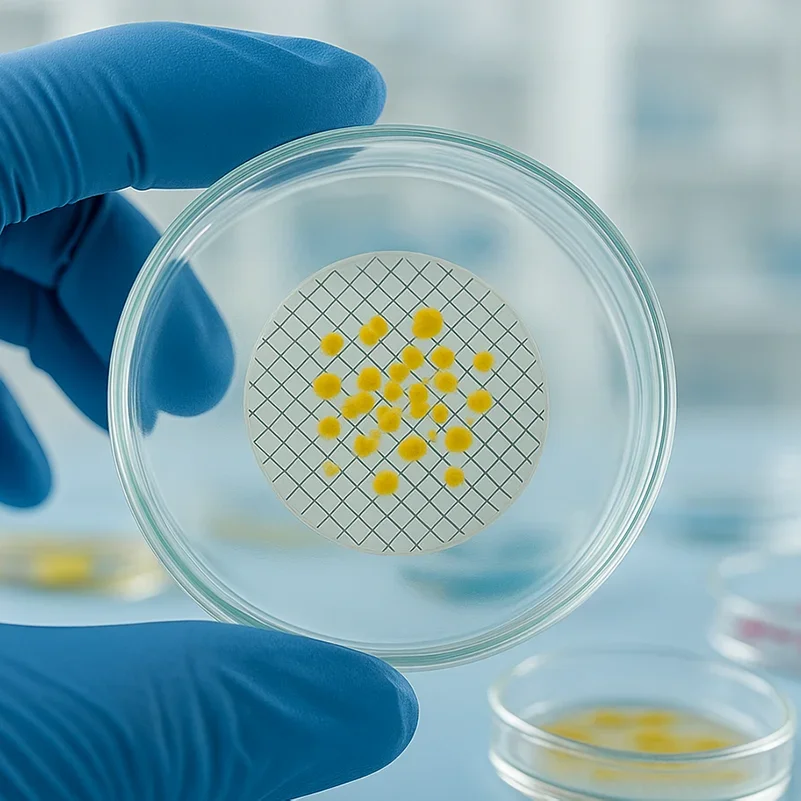
100 шт. мембранный фильтр MCE, смешанные целлюлозные дисковые фильтры, стерильные черные сетчатые гидрофильные фильтры 47 мм 0,45 мкм, индивидуальная упаковка

- дома
- Бестселлеры
-
Все разделы
- Все разделы
- Женская одежда
- Мужская одежда
- Телефоны и аксессуары
- Компьютеры и офис
- Электроника
- Украшения и аксессуары
- Дом и сад
- Багаж и сумки
- Обувь
- Бытовая техника
- Униформа и необычные костюмы
- Аксессуары одежды
- Книги и товары для культуры
- Промышленность и бизнес
- newlv1categorytest
- Ремонт и обустройство
- Автомобили и мотоциклы
- Электронные компоненты и принадлежности
- Всё для свадеб и торжеств
- Спортивная обувь, одежда и аксессуары
- Инструменты
- Мать и ребенок
- Продукты питания
- Игрушки и хобби
- Телефоны и телекоммуникационные аксессуары
- Безопасность и защита
- Test category 06
- Мебель
- Пряди для наращивания и парики
- Наручные часы
- Канцтовары для офиса и дома
- Мотоциклы и оборудование
- Спорт и развлечения
- Нижнее белье
- Красота и здоровье
- Лампы и освещение
- Aliexpress Service Market
- Все магазины